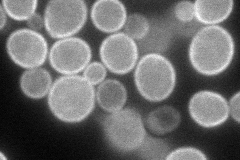
YOR161C
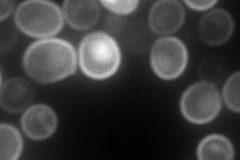
YOR161C
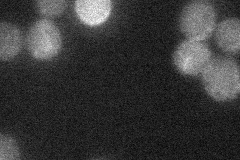
YOR161C
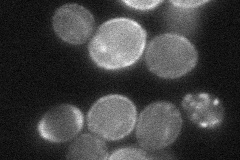
YOR161C
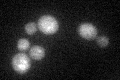
YOR161C
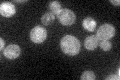
YOR161C

View description
Protein of unknown function; has similarity to Torpedo californica tCTL1p, which is postulated to be a choline transporter, neither null mutation nor overexpression affects choline transport
Localization:
Intensity:
Fold change:
Significance:
-
C’ GFP library in SD

cell periphery18.63 -
N' NOP1pr-GFP in SD
cell periphery111.259 -
N' TEF2pr-mCherry in SD
cell periphery,vacuole173.725 -
N' NATIVEpr-GFP in SD
below threshold23.3911 -
N' TEF2pr-VC and Cyto-VN in SD
cell periphery,punctate45.4842 -
C’ GFP library in SD+DTT
cell periphery20.11.07No -
C’ GFP library in SD+H2O2

cell periphery17.320.93No -
C’ GFP library in Starvation Media
cell periphery45.132.42No -
C’ GFP library on the background of Pup2-DaMP

cell periphery -
C’ GFP library on the background of CCT mutant

cell periphery17.1360.919677No
